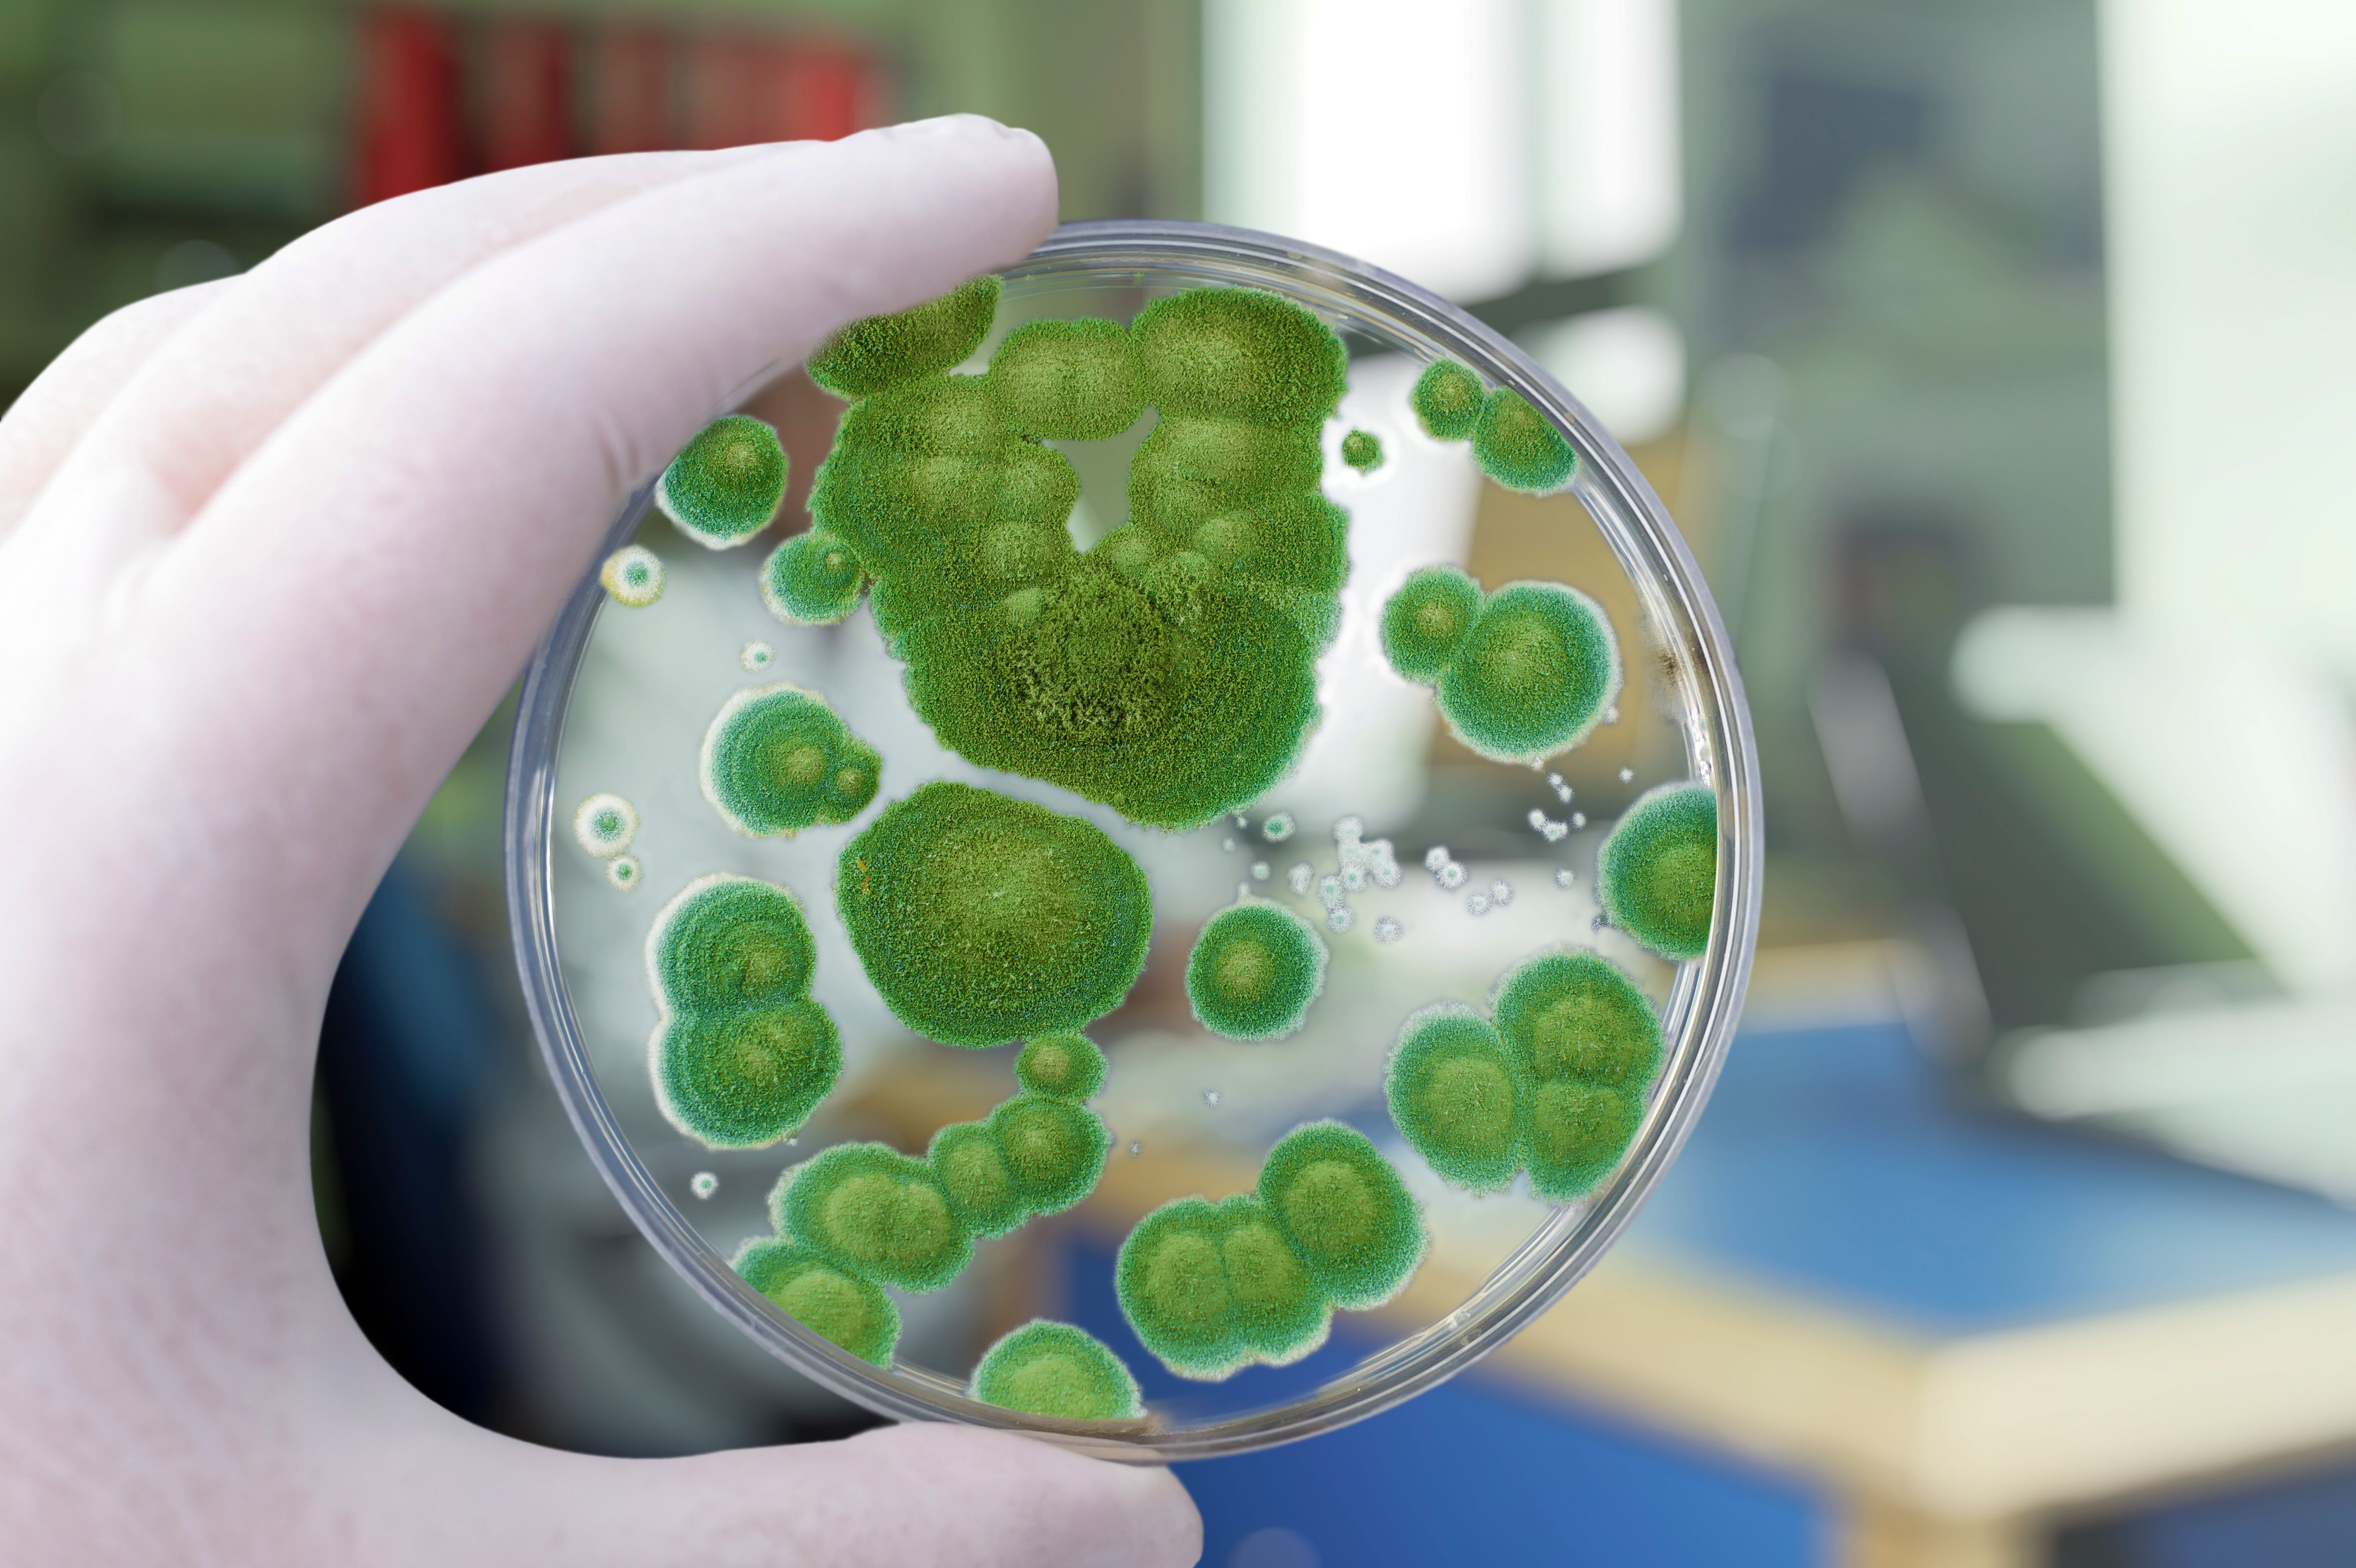
Copyright (c) 2019 Kateryna Kon/Shutterstock

(Wien, 22-11-2023) Die Abteilung „Klinische Mikrobiologie“ am Klinischen Institut für Labormedizin und die Klinische Abteilung für Infektionen und Tropenmedizin an der Universitätsklinik für Innere Medizin I der MedUni Wien wurden gemeinsam als Exzellenz-Zentrum für Medizinische Mykologie der European Confederation of Medical Mycology (ECMM) mit dem höchsten Status (Diamond Status) ausgezeichnet. Ein ECMM Excellence Center (ECMM EC) mit dem Diamond-Status weist eine spezielle Expertise in der Diagnose und Therapie von invasiven Pilzinfektionen auf, ist Teil eines internationalen Kooperationsnetzes und betreibt aktiv hochqualitative Forschung auf dem Gebiet der medizinischen Mykologie.
Akute und chronische Pilzerkrankungen sind oft lebensbedrohlich. Die rechtzeitige Diagnose sowie die Behandlungsmöglichkeiten sind besonders komplex. Ein wachsendes Angebot an diagnostischen Tests, Methoden zum Nachweis von Resistenzen und antimykotischen Wirkstoffen trägt zu dieser Komplexität bei. Die meisten invasiven Pilzinfektionen sind nach der epidemiologischen Definition seltene Krankheiten. Damit fehlt breit gestreutes Wissen, um diese Erkrankungen rasch zu diagnostizieren und die Patient:innen zielgerichtet zu behandeln.
Die enge Kooperation der Ärzt:innen der Abteilung für Klinische Mikrobiologie und der Klinischen Abteilung für Infektionen und Tropenmedizin ermöglicht hier, Abhilfe zu schaffen und invasive Pilzinfektionen rasch zu erkennen und erfolgreich zu behandeln. Auch die Auditoren der ECMM waren neben der hohen Expertise von der ausgesprochen guten Kooperation der beiden Abteilungen beeindruckt.
Beide Abteilungen bieten Beratung und Information beim Auftreten invasiver Pilzinfektionen, beteiligen sich an internationaler Forschung, unterstützen die Ausbildung auf diesem Sektor und leisten damit einen wichtigen Beitrag zur öffentlichen Gesundheit.